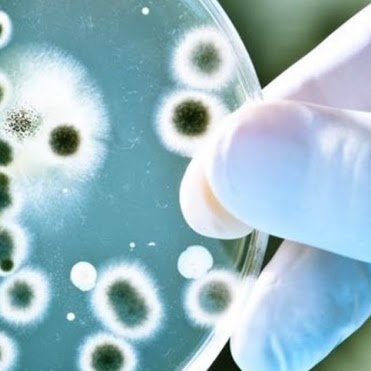

Del cotó als bitllets d’euro
Els alumnes que cursen la matèria d’Economia de 1r de batxillerat han visitat les dependències del Banc d’Espanya, en concret han visitat la sucursal que aquest té a Barcelona. Ha estat una visita molt enriquidora que ha permès a l’alumnat conèixer de primera mà el funcionament de la política monetària a Europa. En la xerrada, […]
Del cotó als bitllets d’euro Llegeix més »